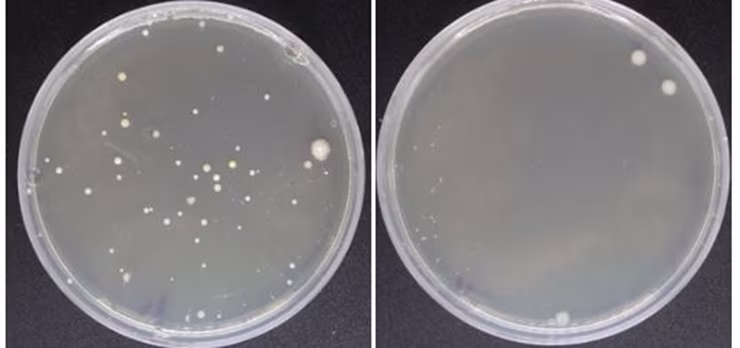
Bacteria from car keys

Unlocking the Facts: A Deep Dive into Car Key Habits, Hygiene and Replacement Costs
Key highlights from the study
A third of drivers (33%) say they have never cleaned their car keys, even though almost one in four (24%) say they’ve owned them for more than five years
Car keys contain almost four times more bacteria than mobile phones and computer keyboards
BMW drivers clean their car keys the most, with almost three in five (57%) cleaning them at least once a week
Half (51%) of Nissan drivers admit to having never cleaned their car keys
One in four (25%) drivers have lost their car keys
15% of drivers don’t own a spare set of car keys
A replacement car key can cost more than £500 for some makes and models
We use them most days, toss them into bags, drop them down the sides of seats and barely give them a second thought. From the bacteria they collect, to the surprising number of drivers who’ve misplaced them, there’s more than meets the eye when it comes to car keys.
In our report, we dive into the world of car keys, uncovering just how dirty they really are through lab testing, surveying drivers on their cleaning routines and lost key mishaps, and comparing key replacement costs across different car brands.
Whether you're a meticulous key-cleaner or someone who never wipes them down, you're about to discover there’s lots to unlock when it comes to the life of your car keys.
For those who are a little careless with their keys, taking out a car insurance policy with car key cover can be a life – and bank account – saver, especially if you don’t have a spare set of keys.
Habits and human behaviour
To better understand drivers’ car key habits, from hygiene to loss and replacement, we surveyed 2,000 motorists. The results offer a fascinating window into how often we clean our keys (or don’t), how often we lose them, and what it costs us when we do.
Our car key cleaning habits
We asked motorists how often they clean common items that get touched frequently, including car keys, mobile phones and computer keyboards.
We discovered that one in three drivers (33%) have never cleaned their keys. However, almost half (49%) clean them at least once a month, and a third (33%) clean them at least once a week.
When compared with other items we handle regularly, car keys are far behind in cleaning routines. While almost one in four (24%) drivers clean their phones daily, only one in six (14%) extend the same habit to their car keys.
The drivers least likely to clean their car keys
Nissan drivers are least likely to clean their keys with a staggering 51% admitting they have never cleaned theirs. This was closely followed by Volkswagen drivers (49%) and Skoda drivers (49%). Over two-fifths of Peugeot (47%) and Kia (43%) drivers also admitted they have never cleaned the keys for their car – despite many of them owning them for years.
The drivers least likely to have cleaned their car keys
Nissan (51%)
Volkswagen (49%)
Skoda (49%)
Peugeot (47%)
Kia (43%)
The drivers who clean their car keys the most
Whether it’s a quick wipe down, or making sure the keys are left sparkling, some motorists don’t want to risk their keys harbouring any bacteria or dirt. In fact, some drivers are very conscious about keeping their keys sparkling clean; almost one in five men (19%) say they clean them daily.
When it comes to makes of car, BMW drivers led the pack in cleanliness, with over half (57%) cleaning their keys weekly or more often. Mercedes-Benz (55%), Land Rover (46%), and Audi (43%) drivers also show a greater tendency to keep their car keys sparkling.
The drivers who clean their car keys the most
BMW (57%)
Mercedes Benz (55%)
Land Rover (46%)
Audi (43%)
Toyota (41%)
Under the microscope: Taking a closer look at our car keys
Image: A close-up of the bacteria found on a set of keys vs the bacteria found on a mobile phone - Lab testing by Microbe Consulting Ltd, May 2025
Washing our hands, wiping down surfaces, scrubbing our bathrooms are common cleaning tasks. But what about those small essentials we handle multiple times a day, like our car keys? They're with us everywhere, from restaurant tables to gym floors, to the depths of our bags, yet they’re often overlooked when it comes to cleaning.
With a third of drivers (33%) admitting they’ve never cleaned their car keys, we wanted to investigate what might be lurking on them.
We enlisted the expertise of Dr Joe Latimer, director at Microbe Consulting Ltd, who collected a variety of car keys from people with different routines and cleaning habits. He swabbed the keys and conducted laboratory analysis to uncover the microbial communities living on these everyday items.
To put the findings in perspective, we also tested the same surface area of:
A mobile phone screen
A computer keyboard
A toilet seat
What We Found
Item | Average bacteria count |
|---|---|
Phone screen | 66 |
Keyboard | 68 |
Car keys | 241 |
Toilet seat | 1,100 |
While it’s no surprise that toilet seats had the highest bacteria count, the real eye-opener was that car keys harboured nearly four times more bacteria than phones or keyboards, items we often assume are the dirtiest in our daily lives and make an effort to clean regularly.
So, what kinds of bacteria are clinging to our keys?
"By far the most abundant bacteria we found on the keys were the very same bacteria we all have happily living on our skin,” explains Joe. “Nearly half of all the bacteria were skin based. On one key, we found nothing but skin bacteria.”
The most common? Staphylococcus epidermidis, a natural resident of human skin.
However, not all the findings were as harmless.
“One of the keys we tested showed signs of bacteria that may have originated in the gut, around 15% of the total bacteria isolated. While unlikely to pose a problem, they can have the potential to carry disease under the right conditions.”
So, if you haven’t cleaned your car keys in a while, a quick wipe down to help rid them of any unwanted bacteria can give you added peace of mind.
How to clean your car keys
For those wanting to give their car keys a clean, there are ways to do it safely.
It’s always best to check with your car manufacturer if you’re unsure how to clean your keys. However, there are some simple ways to do a basic clean.
Use a soft, damp cloth and a mild soap solution to wipe down the exterior, this can help to get rid of grease, grime and germs from the car key fob.
For stubborn dirt or grime, use a toothpick or cotton swab dipped in rubbing alcohol to clean crevices and between the keys.
It’s important to remember to avoid using bleach as modern car keys, especially key fobs, contain electronic components and circuits. Bleach, being a strong chemical, can corrode or damage these components, leading to malfunctions or complete failure.
It’s also important to not submerge the keys into water, as again this could cause issues with any electronic components and circuits, leading to issues with the keys working.
Losing your car keys
It’s extremely annoying when you misplace your car keys, especially if you never find them again. From losing them when you’re out and about or rushing around at home when you’re about to leave – it can be a massive inconvenience and a costly mistake to fix if you need to replace them.
If you have ever misplaced your keys then you’re not alone, as our survey shows that one in four (25%) drivers have lost theirs at some point.
The most common location for lost keys is in the home, with more than one in four (26%) admitting they had been unable to find them before leaving the house. Whether it’s ending up down the side of the sofa, thrown into the pocket of a coat (21%) or being hidden in the depths of a bag (20%), there are lots of ways to lose track of them - one in six (16%) drivers even said they had lost car keys in the car!
Losing your car keys outside of the home can be even more frustrating as you’re unlikely to have immediate access to your spare car key. That means you must figure out how to get home (and in some cases get into the house as well). The drivers we surveyed revealed that they had misplaced them on their commutes, at work, whilst travelling or on holidays and days out with the family.
The most common places we lose our car keys
In the home (36%)
Pockets of clothing (21%)
Handbags or bags (20%)
At a family or friends house (18%)
In the car (17%)
Out of the home whilst shopping (16%)
Whilst commuting or working (13%)
On holiday or whilst travelling (12%)
At the beach or on a day out (12%)
The spare set
For a lot of drivers, having a spare car key means that whilst it’s misplacing their main key is annoying, they can at least get around and on with their lives whilst they wait to find them or replace them.
However, one in six (15%) drivers don’t have a spare set – leaving them stranded when they can’t find their main car keys. Younger drivers are the most likely not to own a backup set, with one in three (31%) not owning more than their main car key.
When it comes to car brands, Fiat drivers are the most likely not to own a spare set, with 27% revealing they only have one set, followed by Land Rover drivers (23%) and Toyota (20%).
The cost of replacement
Losing your keys isn’t just inconvenient, it can also be costly. Four in 10 (44%) people who lost their car key said they’d spent up to £300 on a replacement and nearly one in five (19%) reported shelling out more than £400. Even more shockingly, one in 10 drivers (11%) had spent over £500 on replacements.
These figures highlight how costly car keys have become, especially as more brands adopt digital, coded, or biometric technology in their fobs.
Whether you’ve lost your car keys or damaged them, just how much could you expect to pay out for a new set in 2025?
We researched popular makes and models of cars to reveal some of the priciest replacements. It is worth remembering that the type of key you replace will impact the cost, with remote fob keys (one of the most common types) costing more to replace than a traditional metal key.
The cost of replacing car keys in the UK
Car brand | Car model | Year of car make & model | Cost of replacing original manufacturer key* |
|---|---|---|---|
Fiat | 500 | 2008-2019 | £918 |
Skoda | Octavia | 2015-2018 | £525 |
Toyota | Yaris | 2017-2020 | £512 |
Audi | Q3 | 2015-2018 | £418 |
Volkswagen | Golf plus | 2009-2012 | £399 |
Volvo | S60 | 2010-2016 | £300 |
Hyundai | Tucson | 2019 | £300 |
Land Rover | Defender | 2011-2019 | £300 |
Vauxhall | Corsa | 2019-2025 | £298 |
Ford | Focus | 2018-2023 | £244 |
Peugeot | 207 | 2006-2015 | £237 |
MG | ZS | 2033-2005 | £235 |
Nissan | Juke | 2010-2019 | £218 |
Kia | Ceed | 2019-2020 | £206 |
*estimates via Timpson. Prices vary depending on key type and brand
With the cost of replacement keys being so high for a lot of car brands taking out a car insurance policy with car key protection included can help alleviate worries about the inconvenience and cost of replacing lost car keys.
Methodology
Census wide survey of 2,000 UK drivers, all data correct as of May 2025.
*cost of replacing the manufacturer's original remote key (a genuine manufacturer remote key that includes the car logo), prices based on Timpson (online car key replacement service). Costs accurate as of May 2025.
Lab testing was conducted by Microbe Consulting Ltd, May 2025 – all results correct as of April 2024.